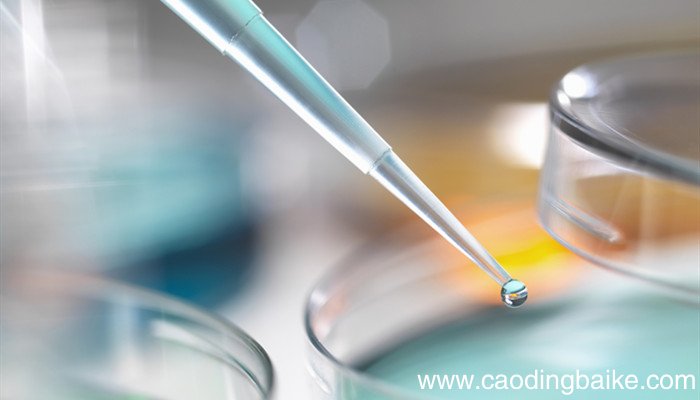
打开浓盐酸的瓶盖有白雾是为什么 打开浓盐酸的瓶口有白雾是为什么

打开浓盐酸的瓶盖有白雾是为什么 打开浓盐酸的瓶口有白雾是为什么
浓盐酸易挥发,挥发出的气体与空气中的水蒸气结合 , 会形成白雾 。盐酸是无色液体 , 具有刺激性气味 。利用盐酸可以与难溶性碱反应的性质 , 制取洁厕灵、除锈剂等日用品 。浓盐酸在工业加工中有着广泛的应用 。浓盐酸稀释有热量放出,需要注意使用规范 。

文章插图
浓盐酸一个最重要的用途是酸洗钢材;在工业中对纯度的要求极高时(如用于食品、制药及饮用水等) , 常用高纯的盐酸来调节水流的pH值 。
文章插图
浓盐酸还有许多小规模的用途,比如皮革加工、食盐生产,以及用于建筑业;可以溶解碳酸钙,包括除水垢或砌砖使用的石灰砂浆 , 但盐酸较为危险,使用时需谨慎 。
浓盐酸会挥发出酸雾,会腐蚀人体组织,可能会不可逆地损伤呼吸器官、眼部、皮肤和胃肠等 , 如果接触到皮肤,需立即用大量清水冲洗,然后去医院治疗 。

文章插图
【打开浓盐酸的瓶盖有白雾是为什么 打开浓盐酸的瓶口有白雾是为什么】浓盐酸需要储存在阴凉、通风的库房,保持容器密封 , 应与碱类、胺类、碱金属、易燃物分开存放 。
- 年味浓浓的结尾有什么特点 年味浓浓的结尾的特点有什么
- 硝酸银溶液与稀盐酸反应的化学方程式 硝酸银溶液与稀盐酸反应方程式
- 氢氧化钠和稀盐酸反应 氢氧化钠加稀盐酸现象
- 为什么雍正墓没有被盗 雍正墓为什么不打开
- 浓度95的酒精怎么稀释成75的浓度95的酒精怎么稀释成75的方法
- 锌与稀盐酸反应的现象 锌与稀盐酸反应的现象是什么
- 盐酸与氢氧化钾反应的化学方程式 盐酸与氢氧化钾反应现象
- 氢氧化铝与稀盐酸反应的化学方程式 氢氧化铝与稀盐酸反应方程式
- 打开天窗说亮话和直言不讳表达效果有什么不同 打开天窗说亮话和直言不讳有什么不同
- 超级好看的浓浓端午节手抄报 端午节手抄报
